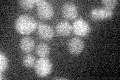
YLR261C
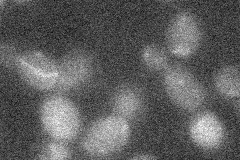
YLR261C
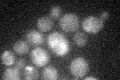
YLR261C

View description
Dubious open reading frame, unlikely to encode a protein; not conserved in closely related Saccharomyces species; 98% of ORF overlaps the verified gene YPT6; deletion causes a vacuolar protein sorting defect
Localization:
Intensity:
Fold change:
Significance:
-
C’ GFP library in SD
below threshold13.89 -
N' NOP1pr-GFP in SD

nucleus24.7875 -
N' TEF2pr-mCherry in SD

missing0 -
N' NATIVEpr-GFP in SD
below threshold26.8633 -
N' TEF2pr-VC and Cyto-VN in SD

#N/A0 -
C’ GFP library in SD+DTT

cytosol17.651.27No -
C’ GFP library in SD+H2O2
cytosol16.221.16No -
C’ GFP library in Starvation Media

cytosol16.11.15No -
C’ GFP library on the background of Pup2-DaMP

below threshold -
C’ GFP library on the background of CCT mutant

below threshold15.93481.14642No
